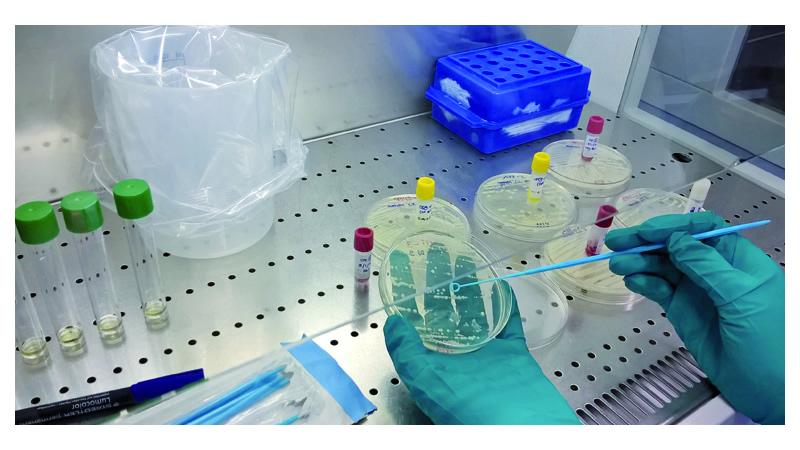
tratamiento del agua

Drinking Water Library es la primera base de datos para la técnica MALDI-TOF MS específica para bacterias presentes en aguas de consumo. Esta colección, formada por 320 cepas diferentes, es una herramienta de apoyo para el control microbiológico rutinario que se realiza en las operadoras de tratamiento y distribución de agua, ya sea potabilizada o embotellada, ya que ayuda a caracterizar microbiológicamente el agua de suministro.
Las aguas de consumo humano, ya sean potabilizadas o embotelladas, no son estériles sino que contienen microorganismos ambientales. Si bien la presencia de determinados indicadores bacterianos, como Escherichia coli, Clostridium perfringens y Enterococcus sp. está regulada en el RD 140/2003 para proteger la salud del consumidor, muchos otros representantes de la microbiota del ecosistema de donde procede el agua pueden estar presentes.
Aunque no necesariamente representen un problema para la salud, conocer la composición microbiológica de toda esta microbiota es importante para mejorar los sistemas de tratamiento y distribución de aguas destinadas al consumo humano.
El proyecto Drinking Water Library, desarrollado entre octubre 2015 y diciembre 2018 mediante la colaboración de Aigües de Barcelona, la Fundació Bosch i Gimpera-Universidad de Barcelona (FBG-UB), la Colección Española de Cultivos Tipo (CECT)-Universidad de Valencia, el Centro Tecnológico del Agua (Cetaqua) y la participación de la empresa Bruker, ha permitido desarrollar la primera base de datos para MALDI-TOF MS específica para bacterias presentes en aguas de consumo.
Espectometría de masas
La espectrometría de masas MALDI-TOF MS (Matrix-Assisted Laser Desorption/Ionization-Time-Of-Flight Mass Spectrometry) es una técnica utilizada para obtener un espectro propio de un microorganismo y, comparándolo con bases de datos, identificarlo en su género, especie e incluso cepa.
Es una técnica rápida, sencilla de aplicar y robusta en cuanto a la fiabilidad de resultados, que hasta el momento no se habia desarrollado para el sector ambiental, y que tiene gran potencial para avanzar en el conocimiento de la microbiología del agua potable. La identificación mediante MALDI-TOF MS requiere de cultivos en placa, por lo que la identificación no es inmediata. Pero una vez las bacterias han crecido en placas de cultivo, la identificación se realiza en unos pocos minutos.

Con el proyecto Drinking Water Library (DWL) se ha creado una base de datos de perfiles MALDI-TOF MS para bacterias acuáticas, que permite identificar 320 cepas bacterianas presentes en aguas de consumo: aguas de proceso, red de distribución, asi como manantiales y embotelladas. Esta colección de cepas, todas ellas accesibles en la Colección Española de Cultivos Tipo (CECT) es una herramienta de apoyo para el control microbiológico rutinario que realizan las operadoras de tratamiento y distribución de agua, ya sea potabilizada o embotellada.
Drinking Water Library (DWL)
En el catálogo de la CECT correspondiente a depósitos públicos, se buscaron cepas pertenecientes a géneros o especies asociadas al agua de consumo humano. Se obtuvieron 199 cepas, de las que se crearon sus respectivos perfiles Main Spectrum Profile (MSP).
Y, por otra parte, durante el proyecto se generaron aislados a partir de puntos de muestreo: 45 aislados procedentes de red de distribución, 29 aislados de aguas de procesos de potabilización, 35 aislados procedentes de aguas embotelladas y 12 procedentes de manantial. Las cepas bacterianas aisladas de muestras ambientales de agua se analizaron utilizando la base de datos comercial de Bruker Daltonics.
La base de datos DWL, ha quedado compuesta por 320 MSP, de los cuales 199 MSP pertenecen a cepas de referencia iniciales de la CECT y 121 MSP corresponden a los aislados generados durante el proyecto.

Los géneros que incluyen más cepas en la nueva base de datos de bacterias de aguas de consumo DWL son Aeromonas, Chryseobacterium, Flavobacterium, Sphingomonas y Methylobacterium. A nivel de especie, la DWL aporta 189 especies no representadas en la base de datos comercial de Bruker, de las cuales 69 son posibles nuevos taxones, incrementándose el potencial de identificación de aislados acuáticos.
Por su aportación para identificar de forma rápida y fiable las bacterias asociadas al agua, Drinking Water Library puede ser una herramienta de gran utilidad para laboratorios de aguas, empresas suministradoras de agua, universidades, centros de investigación y usuarios de MALDI-TOF MS.
Fuente: Artículo Drinking Water Library: nuevo recurso para identificar cepas bacterianas en aguas de consumo, publicado en TecnoAqua
Autores: Belén Galofre; Carles Vilaró, Sonia Fernández; David Baquero; Susana González, Anicet R. Blanch; Francisco Lucena; Cristina García-Aljaro; Laura Sala-Comorera; Daniel Toribio, Maria A. Ruvira; Lidia Rodrigo-Torres; M. Carmen Macián; David R. Arahal; Maria J. Pujalte; Rosa Aznar